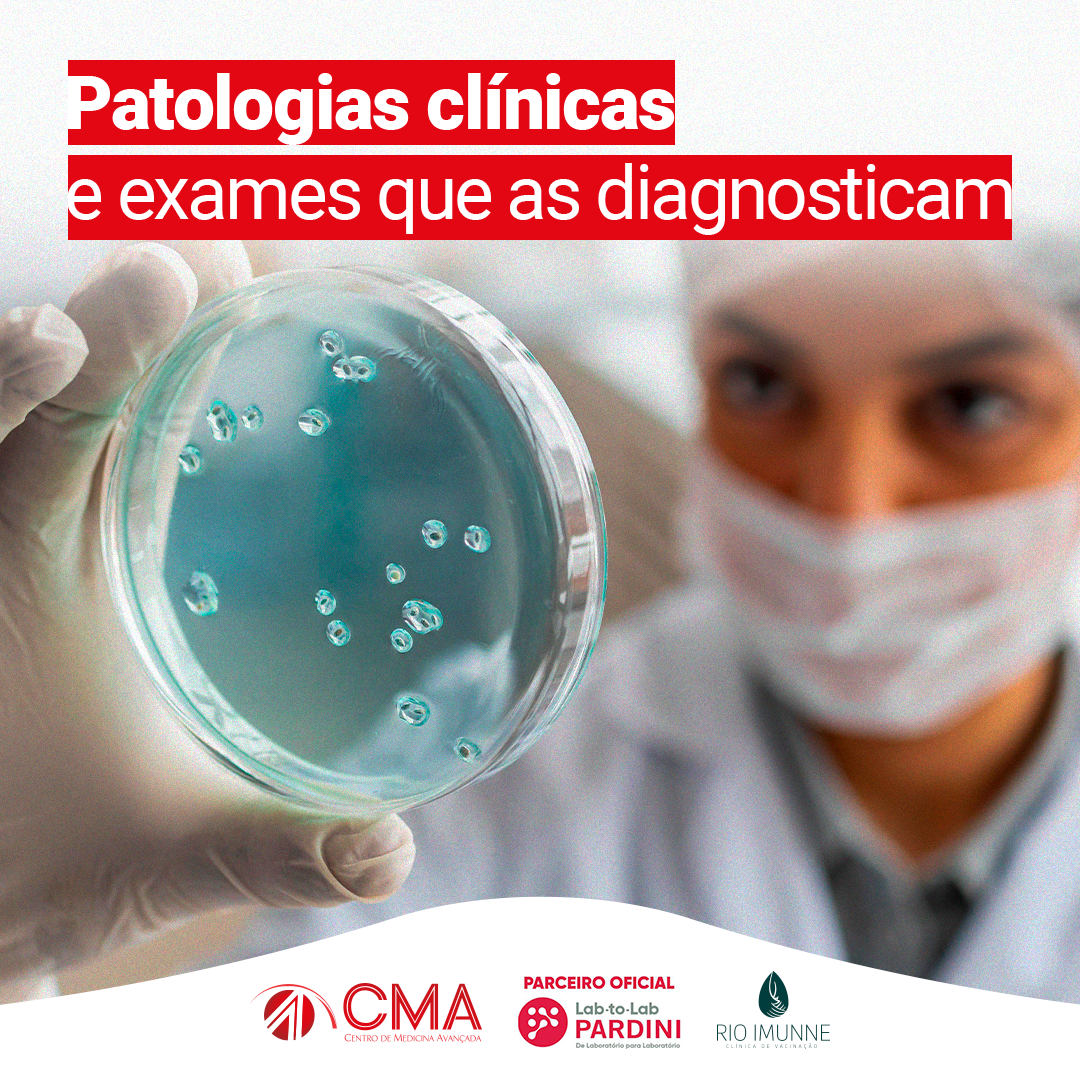

Destaques - Patologias Clínicas
Patologias Clínicas
As patologias clínicas abrangem o tratamento de diversas doenças por meio da análise de exames laboratoriais e da interpretação dos seus resultados. ✅
➡️ Sendo assim, é possível prevenir, diagnosticar precocemente e tratar de maneira eficaz variadas condições através da realização de exames laboratoriais.
Os exames mais solicitados para o diagnóstico e acompanhamento destas condições são:
✴️ Hemograma;
✴️ Perfil lipídico;
✴️ Hemoglobina A1c;
✴️ Exame de urina;
✴️ Exames hormonais;
Não deixe de realizar seus exames e mantenha a sua saúde em dia!
Compartilhe